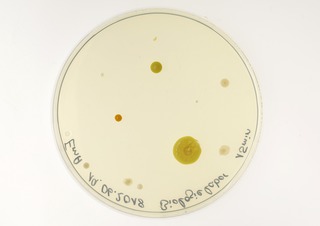

mittendrin - TU Dortmund
Engineering meets Art
<h1>Engineering meets Art</h1>
<h2>Kunst, Musik und Bio- & Chemieingenieurwesen</h2>
<p>"Engineering meets Art“ war eine Kooperation der Fakultät Bio- und Chemieingenieurwesen (BCI) mit dem Arbeitsbereich Fotografie am Seminar für Kunst & Kunstwissenschaft und dem Institut für Musik und Musikwissenschaft der TU Dortmund. Über 2 Semester arbeiteten...</p>
Engineering meets Art
Kunst, Musik und Bio- & Chemieingenieurwesen
"Engineering meets Art“ war eine Kooperation der Fakultät Bio- und Chemieingenieurwesen (BCI) mit dem Arbeitsbereich Fotografie am Seminar für Kunst & Kunstwissenschaft und dem Institut für Musik und Musikwissenschaft der TU Dortmund. Über 2 Semester arbeiteten Studierende der Fotografie und jene der Musik erstmals gemeinsam mit den Studierenden des BCI zusammen und entwickelten komplexe Strategien, um Ingenieurwesen und Kunst zu vereinen. Dabei lernten tote Bienen fliegen, fotografischer Film ging sich selbst unter die Haut, Melodien von Insulin erklangen und Schallwellen wurden sichtbar. Diese und viele weitere herausragende Projekte wurden schließlich in einer Ausstellung im Mai und Juni 2019 auf der Hochschuletage/Campus Stadt der TU Dortmund im Dortmunder U präsentiert und von einem Katalog begleitet.

<h2>Ausstellungsansichten im Dortmunder U</h2>
Einsicht in den Katalog

<h1>Welten</h1>
<h2>Janis-Julia Finke</h2>
<p>Die Biochemie untersucht chemische Zusammensetzungen von Organismen und chemische Vorgänge in diesen. Dazu werden häufig Petrischalen verwendet; dort werden bakterielle...</p>



<h1>Die Unwiederholbarkeit des
Moments (im Fluss des zeitlichen
Geschehens)</h1>
<h2>Alexander Gunkel</h2>
<p>Manche Veränderung kann niemand mehr rückgängig machen. Manche Momente sind unwiederholbar. Ingenieurinnen und Ingenieure besitzen den geheimnisvollen...</p>



<h1>Grund</h1>
<h2>Jens Bednarz</h2>
<p>Wenn wir vom Boden sprechen, geht es nie nur um den Aspekt des Laufuntergrundes, sondern vielmehr um eine spezifische Funktion, die er in seinem Kontext erfüllt...</p>

<h1>Der erste und letzte Tag</h1>
<h2>Jonas Tilly</h2>
<p>Strömungen entstehen aus Wechselwirkungen von Unmengen winziger Teilchen. Zur akkuraten Berechnung von Strömungen werden extrem rechenintensive mathematische Modelle...</p>
<h1>Invisibilia species</h1>
<h2>KATRIN STÜER-PATOWSKY</h2>
<p>Die makroskopisch sichtbare Welt, in der wir uns jeden Tag bewegen, ist zugleich Schauplatz vieler mikroskopischer Lebensgemeinschaften. In der Arbeit der Bioingenieurin...</p>

<h1>Zoom in</h1>
<h2>Lukas Seppelfricke</h2>
<p>Ein Raster-Elektronen-Mikroskop (REM) ermöglicht eine sehr genaue Betrachtung von Werkstoffoberflächen. Untersucht man damit einen belichteten, aber unentwickelten 35 mm-...</p>

<h1>In the Spotlight</h1>
<h2>Marcel Scholz</h2>
<p>Forschung bedarf geeigneter Technik, Instrumente oder speziell angefertigter Maschinen. In ihrer Dienstzeit für die Wissenschaft werden diese gewartet, gereinigt oder repariert...</p>

<h1>Sur-face</h1>
<h2>Marie Schütte</h2>
<p>Die äußere Erscheinung von Dingen bestimmt, wie diese gesehen werden. Doch nicht alles, was vorhanden ist, wird auch wahrgenommen. So ist die menschliche Oberfläche...</p>

<h1>Grow to Stone (Iwao to Narite)</h1>
<h2>Marvin Eil</h2>
<p>Um wieviel wachsen Kieselsteine in 200.000 Jahren? Wieviel Moos wächst auf ihnen in dieser Zeit? Was bedeutet Zeit für Bernsteinsäurekristalle? Was bedeutet sie für Menschen?...</p>

<h1>The Structure of Bark</h1>
<h2>Nana Seeber</h2>
<p>Ein Raster-Elektronen-Mikroskop (REM) vergrößert Strukturen bis zu 100.000-fach. Solche mikrokosmischen Dimensionen bleiben dem bloßen Auge verschlossen...</p>

<h1>Todestanz</h1>
<h2>Pia van den Wyenbergh</h2>
<p>Angeregt durch die Debatte um die in der Landwirtschaft verwandten Neonicotinoide, die das Insektensterben drastisch vorantreiben, entstand das Werk „Todestanz“...</p>

<h1>Aequorea victoria</h1>
<h2>Stefanie Muno & Nina Felsmann</h2>
<p>Gentechnik kann Organismen verändern. Was vielen Menschen Angst macht, kann doch auch zu ihrem Nutzen sein. Die Fotografien zeigen die in der Forschung häufig verwendeten...</p>



JavaScript is turned off.
Please enable JavaScript to view this site properly.